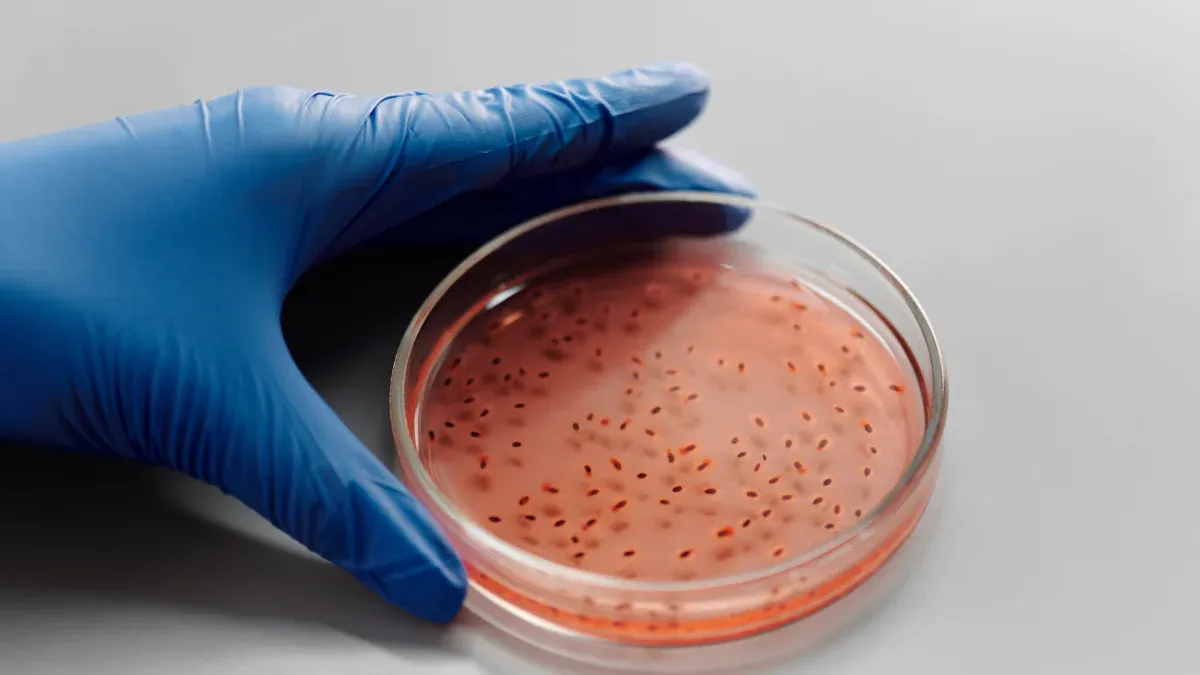
Методологія імунохроматографічного методу комбінованого тесту Vibro Cholerae O139 та O1

TheКомбінація Vibro Cholerae O139 (VC O139) та O1 (VC O1)Тест використовує метод імунохроматографії для ідентифікації двох значущих штамів холерних бактерій. Цей тест має вирішальне значення для своєчасного виявлення холери, що дозволяє органам охорони здоров'я вживати швидких заходів. Ефективне використання комбінації Vibro Cholerae O139(VC O139) та O1(VC O1) покращує управління спалахами, зрештою знижуючи рівень захворюваності та смертності, пов'язаних з холерою.
| Рік | Повідомлені випадки | Повідомлення про смертельні випадки | Зміна кількості смертей |
|---|---|---|---|
| 2023 рік | 535 321 | 4000 | +71% |
Ключові висновки
- TheКомбінований тест Vibro Cholerae O139 та O1дозволяє швидко виявляти штами холери, що забезпечує швидке реагування органів охорони здоров'я.
- Ефективний збір зразків та належні процедури тестування мають вирішальне значення для точної діагностики холери та боротьби зі спалахами.
- Нещодавні інновації в тестуванні, такі як швидкі діагностичні тести, значно покращують швидкість виявлення та посилюють зусилля з епіднагляду за холерою.
Методологія імунохроматографічного методу комбінованого тесту Vibro Cholerae O139 та O1
Методи збору зразків
Ефективний збір зразків є життєво важливим для точного тестування на холеру. Медичні працівники повинні дотримуватися певних протоколів для забезпечення цілісності зразків. Рекомендовані практики включають:
- Зразки калуЗібрати від 4 до 10 зразків калу у пацієнтів з підозрою на холеру. Ці зразки необхідно надіслати до мікробіологічної лабораторії для підтвердження, ідентифікації штаму та оцінки чутливості до антибіотиків.
- Транспортні медіаУзгодьте з лабораторією бажані транспортні середовища. Варіанти можуть включати фільтрувальний папір або матеріал Кері-Блера, які допомагають зберегти життєздатність зразків під час транспортування.
Процедури тестування
Комбінований тест Vibro Cholerae O139(VC O139) та O1(VC O1) використовує метод імунохроматографії, який дозволяє швидко виявляти штами холери. Для проведення тесту необхідно таке обладнання та реагенти:
| Обладнання/Реагенти | Опис |
|---|---|
| Експрес-тест StrongStep® Vibrio cholerae O1/O139 Combo Antigen Combo | Швидкий візуальний імуноферментний аналіз для якісного виявлення Vibrio cholerae O1 та/або O139 у зразках людського калу. |
| Антитіла проти холерного вібріону O1/O139 | Іммобілізований на тестовій ділянці мембрани для виявлення. |
| Кольорові частинки | Кон'югований з антитілами для візуальної інтерпретації результатів. |
| Зразок | Зразки людського калу, які необхідно дослідити одразу після збору. |
| Умови зберігання | Зберігайте набір при температурі 4-30°C, не заморожуйте та захищайте від забруднення. |
Процес тестування включає нанесення зразка калу на тестовий пристрій, де він взаємодіє з антитілами. Видима лінія вказує на наявність бактерій холери, що дозволяє швидко поставити діагноз.
Чутливість та специфічність
Чутливість та специфічність комбінованого тесту Vibro Cholerae O139 та O1 є критично важливими показниками для оцінки його ефективності. Нещодавні клінічні дослідження повідомляють про такі показники:
| Тип тесту | Чутливість | Специфічність |
|---|---|---|
| V. cholerae O139 (фільтровані зразки) | 1,5 × 10² КУО/мл | 100% |
| V. cholerae O139 (нефільтровані зразки) | На один лог нижче, ніж відфільтровано | 100% |
Крім того, об'єднані показники чутливості та специфічності швидких діагностичних тестів на холеру показують:
| Тип тесту | Об'єднана чутливість | Об'єднана специфічність |
|---|---|---|
| Швидкі діагностичні тести на холеру | 90% (від 86% до 93%) | 91% (від 87% до 94%) |
Ці високі показники свідчать про те, що метод імунохроматографії з використанням комбінованого тесту Vibro Cholerae O139 (VC O139) та O1 (VC O1) забезпечує надійні результати, що робить його цінним інструментом у виявленні холери та управлінні спалахами.
Важливість у громадському здоров'ї

Роль у боротьбі зі спалахами
TheКомбінований тест Vibro Cholerae O139 та O1відіграє ключову роль у боротьбі зі спалахами холери. Швидке виявлення штамів холери дозволяє органам охорони здоров'я своєчасно вживати заходів. Цей тест значно підвищує швидкість та ефективність реагування громадського здоров'я.
- Посилений скринінгВпровадження швидких діагностичних тестів (ШДТ) призвело до посилення скринінгу на холеру. У громадах, які раніше вважалися вільними від холери, тепер спостерігаються випадки захворювання завдяки покращеним можливостям виявлення.
- Економічно ефективність: ШТД є більш економічно ефективними та менш трудомісткими, ніж традиційні лабораторні тести. Ця ефективність сприяє швидшій діагностиці та лікуванню, що є вирішальним під час спалахів.
- Негайні результатиНові експрес-тести надають результати за лічені хвилини, що значно швидше, ніж традиційні лабораторні аналізи, які можуть тривати кілька днів. Такий швидкий результат є важливим для запобігання подальшим інфекціям та своєчасного початку кампаній вакцинації.
У наступній таблиці показано чутливість та показники позитивного виявлення різних методів виявлення холери, що підкреслює переваги комбінованого тесту Vibro Cholerae O139 та O1:
| Метод | Чутливість (%) | Специфічність (%) | Коефіцієнт позитивного виявлення (%) |
|---|---|---|---|
| ІФАГ | 19.9 | Високий | 29/146 |
| Традиційна культура | 10.3 | Нижня | 15/146 |
| ПЛР у реальному часі | 29,5 | Найвищий | 43/146 |

Тематичні дослідження ефективного використання
Тематичні дослідження демонструють ефективність комбінованого тесту Vibro Cholerae O139 та O1 у різних регіонах. Наприклад, дослідження вказують на значні відмінності в рівнях стійкості до антибіотиків між штамами Vibrio cholerae O139 та O1. Штами O1 часто пов'язані з великими спалахами, тоді як штами O139, як правило, пов'язані зі спорадичними випадками та спалахами харчового отруєння. Розуміння цих закономірностей має вирішальне значення для боротьби з епідеміями холери, особливо у вразливих районах, таких як сільська місцевість Бангладеш.
Наслідки для глобального здоров'я
Глобальний тягар холери залишається значним, вражаючи приблизно 1,3 мільярда людей, причому більшість випадків зосереджена в країнах Африки на південь від Сахари та Південній Азії. Спалахи часто стають масштабними та тривалими, про що свідчать такі країни, як Ємен та Гаїті. Традиційні діагностичні методи, що є золотим стандартом, включаючи мікробне культивування та ПЛР, вимагають значного часу, кваліфікованого персоналу та лабораторної інфраструктури, що часто призводить до затримок у підтвердженні спалаху та реагуванні на нього. Ці обмеження сприяють підвищенню захворюваності та смертності та перешкоджають точній оцінці тягаря холери, створюючи додаткове навантаження на здоров'я та економіку уражених регіонів.
У цьому контексті експрес-діагностичні тести (ШДТ) на основі імунохроматографії пропонують трансформаційний підхід. Виявляючи антигени Vibrio cholerae O1 та O139 за допомогою імуноферментного аналізу з латеральним потоком, ці тести дають якісні результати протягом 5 хвилин, не вимагаючи зберігання в холодному ланцюгу або складного обладнання. Їх можна проводити з мінімальним навчанням у місці надання медичної допомоги, що робить їх особливо цінними у віддалених умовах та з обмеженими ресурсами. Хоча ШДТ не призначені для остаточної діагностики пацієнтів, вони мають високу негативну прогностичну цінність, що зменшує потребу в підтверджуючих тестах у районах з низькою поширеністю. Їх основне застосування полягає в епідеміологічному спостереженні, де їхня швидкість та економічна ефективність дозволяють раннє виявлення спалахів, кращий моніторинг просторово-часових тенденцій та ефективніше впровадження таких заходів, як пероральні холерні вакцини (ПХВ) та санітарні заходи, що особливо важливо, враховуючи поточну обмежену світову пропозицію ПХВ.
Наслідки впровадження імунохроматографії є далекосяжними: покращений епіднагляд у режимі реального часу підвищує точність прогнозування та оптимізує реагування на спалахи; стандартизація визначень випадків у різних країнах стає більш можливою завдяки гармонізованому швидкому тестуванню; а отримані потоки даних можна інтегрувати зі штучним інтелектом для глибшого аналізу динаміки передачі. Зрештою, ці інновації є важливими для просування глобальної боротьби з холерою, зменшення смертності, якої можна було б запобігти, та пом'якшення наслідків для здоров'я та економіки вразливих груп населення.
TheКомбінований тест Vibro Cholerae O139 та O1відіграє життєво важливу роль у виявленні холери. Він надійно ідентифікує штами холери, що дозволяє швидко реагувати на неї в галузі охорони здоров'я. Завдяки чутливості виявлення всього 10³ клітинХолерний вібріон, цей тест виявляється важливим у боротьбі зі спалахами.
Підвищення обізнаності та використання цього тесту серед медичних працівників має вирішальне значення. У наступній таблиці наведено поширеність та стійкість до антибіотиків серогруп холери:
| Серогрупа | Поширеність (%) | Резистентність до антибіотиків (%) |
|---|---|---|
| O1 | Високий | 70% (цефотаксим), 62,4% (триметоприм-сульфаметоксазол), 56,8% (ампіцилін) |
| О139 | Помірний | Немає даних |
Органи охорони здоров'я повинні надати цьому тесту пріоритет, щоб посилити зусилля з боротьби з холерою в усьому світі.
Найчастіші запитання
Яке основне призначення комбінованого тесту Vibro Cholerae O139 та O1?
Тест швидко виявляє штами холери, що дозволяє своєчасно вживати заходів охорони здоров'я.
Скільки часу потрібно, щоб отримати результати комбінованого тесту?
Зчитайте результати через 5 хвилин. Не інтерпретуйте результат після 10 хвилин.
Так, тест може одночасно виявити штами Vibrio cholerae O1 та O139 в одному зразку.
Час публікації: 05 вересня 2025 р.

